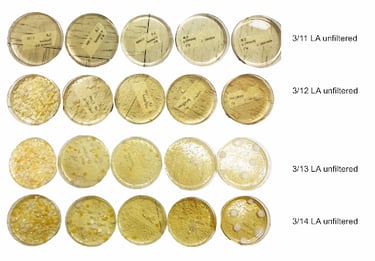

2024 - 2025 RIG
Water Filtration
This research project investigates the efficacy of decentralized water treatment techniques, specifically focusing on the use of Moringa oleifera seeds as a natural coagulant and the comparative effectiveness of boiling versus aluminum sulfate for pathogen neutralization. The study aims to identify accessible, scalable solutions for improving water quality in regions lacking established potable water infrastructure.

DC to AC Inverter
This engineering project focuses on the development of a power electronic system capable of converting Direct Current (DC) into manageable Alternating Current (AC). The research explores the integration of advanced modulation techniques and hardware design to ensure high-efficiency power conversion for modern electrical applications.




Lean Legends
This dual-track industrial engineering project focuses on enhancing production efficiency through two distinct initiatives: the standardization of lot size metrics for injection molding and the implementation of Lean Manufacturing methodologies within the weather seal production line.




